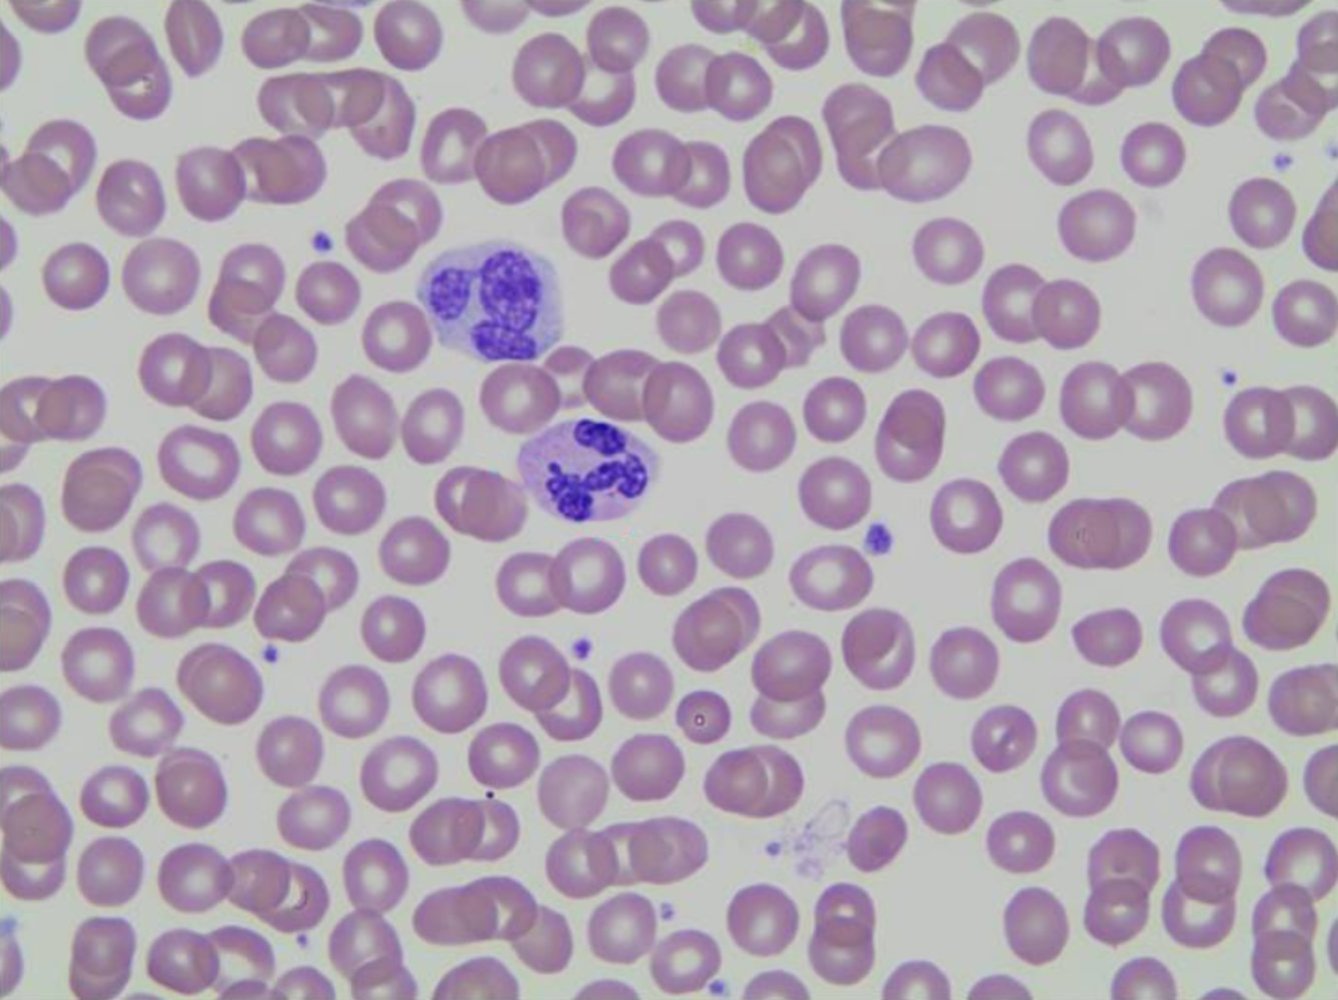

Human genetics is the study of the human genome and the transmission of genes from one generation to the next. The human genome consists of 23 pairs of chromosomes (22 pairs of homologous chromosomes and one pair of sex chromosomes). All homologous chromosome pairs contain two variant forms of the same gene, called “alleles,” which are passed down from parent to offspring. Genetic disorders result from new or inherited gene mutations. Epigenetic regulation of gene expression encompasses mechanisms that allow regulating the expression of the genes without modification of the DNA sequence. Hereditary disorders are passed down from parent to offspring via different patterns of inheritance, including autosomal dominant, autosomal recessive, X-linked, and mitochondrial inheritance.
For an overview of DNA and RNA structure, see “Nucleotides, DNA, and RNA.”

Genes
- Gene: a DNA segment with a nucleotide sequence encoding an RNA product that is either directly functional or encodes a protein
- Locus: location of a gene or a particular DNA sequence (e.g., promoter) on a chromosome
-
Allele: one of the variant forms a gene can have in a population (from a particular locus)
- Wild-type allele: the allele that encodes for the most common phenotype in a population
- Mutant allele: any allele that does not code for the most common phenotype in a population
- Multiple alleles: the occurrence of more than two different alleles in a population (e.g., the ABO blood group system) [1]
-
Allele frequency: the prevalence of a particular allele at a genetic locus within a population
- Examples
- In a population of 250 individuals, there will be a total of 500 gene copies (all individuals carry two alleles of a gene).
- If 10 individuals of this population are homozygotes and 30 are heterozygotes for a certain mutant allele, then the total number of mutant copies is (10 x 2) + (30 x 1) = 50.
- The allele frequency of the mutant allele will be 50/500 = 0.01 = 1%.
- Examples
- Genetic polymorphism: a gene with more than one allele occupying the same locus of that gene [2]
Chromosomes
-
Chromosome: a structure found in the nucleus of eukaryotic cells that contains nucleic acids and associated proteins (e.g., nucleosomes)
- Contains part or all of the genetic information for a given organism
- Each human cell contains 23 pairs of homologous chromosomes (corresponding in structure and genetic information, i.e., 23 chromosomes are inherited from each parent).
- Germ cells only carry one-half of a somatic cell's chromosomes.
- Can be visualized under a microscope during metaphase
-
Allosome (sex chromosome)
- A type of chromosome that carries the genes that determine chromosomal sex (see “Development of the reproductive system”)
- Human cells contain one pair of allosomes: XX in female individuals and XY in male individuals
-
Autosome
- Any chromosome of a cell genome that is not an allosome
- Human cells contain 22 pairs of homologous autosomes.
-
Ploidy: the number of chromosome sets present in a cell
- Haploid cell: contains one single unpaired set of chromosomes (n = 23)
- Diploid cell: carries a complete set of paired chromosomes (2n = 46)
- Chromatid: one of the two identical strands of a replicated chromosome
- Sister chromatids: two identical chromatids joined at the centromere (i.e., the duplicated chromosome)
-
Centromere: a condensed region of chromosomes where sister chromatids join
- Divides the chromatids into a short p arm and a long q arm
- Mediates attachment of the chromosome to the meiotic or mitotic spindle.
- Depending on the centromere position, a chromosome can be:
- Metacentric: The p and q arms are of approximately identical length.
- Submetacentric: The p arm is short and the q arm is long.
- Acrocentric: The p arm is much shorter than the q arm.
- Kinetochore: a protein complex found at the centromere that allows for the attachment of mitotic spindle microtubules during mitosis
-
Telomere
- Repetitive, noncoding DNA sequence at the ends of each chromosome, which prevents the loss of coding DNA sequences during DNA replication
- Telomere shortening occurs after each cell division, which can reduce a cell's life span.
The mitotic spindle attaches to the kinetochores, not the centromeres.


Genotype and phenotype
-
Genotype: the chemical composition of an organism's DNA, contributing to that organism's phenotype
- The term is often used to describe a combination of alleles at one or more specific loci.
- Based on the genotype, the following states (zygosities) can be distinguished:
- Homozygote: The two homologous chromosomes contain identical alleles at a given locus.
- Heterozygote: The two homologous chromosomes contain different alleles at a given locus.
- Hemizygote: having only one copy of a chromosome pair (e.g., genes located on a male individual's X or Y chromosomes).
-
Phenotype: the observable traits of an organism
- Determined by a combination of the genotype and environmental factors
- Includes an individual's physical traits (e.g., eye or hair color) and physiological characteristics (e.g., atopy)
-
Dominance: the characteristic of an allele to mask or override the phenotypical effects of the allele on the other corresponding copy of the chromosome in heterozygous individuals
- Dominant allele: the allele which is phenotypically apparent in heterozygous individuals (overrides the phenotypical effects of the corresponding allele in heterozygous individuals)
- Recessive allele: an allele whose effects are overridden by the corresponding dominant allele in heterozygous individuals
-
Codominance: a state in which both alleles are fully expressed and contribute to the heterozygote phenotype
- Examples
- ABO blood group system
- Human leukocyte antigens (HLA)
- α1-antitrypsin deficiency
- Examples
- Incomplete dominance: a type of dominance in which the dominant allele fails to completely override the phenotypic expression of the recessive allele, thus producing a new intermediate phenotypic trait (e.g., sickle cell trait)
Compared to dominant alleles, that have the same phenotypical expression regardless of the zygosity, codominant alleles express two completely different phenotypes in homozygous and heterozygous individuals.
Genetic penetrance and expressivity
| Types of genetic penetrance and expressivity | ||
|---|---|---|
| Mechanism | Definition | Example |
| Penetrance |
|
|
| Complete penetrance |
|
|
| Incomplete penetrance |
|
|
| Expressivity |
|
|
| Variable expressivity |
|
|
| Pleiotropy |
|
|
| Compound heterozygosity |
|
|
| Anticipation (genetics) |
|
|
| Allelic heterogeneity |
|
|
| Locus heterogeneity |
|
|
| Linkage disequilibrium |
|
|
| Epistasis |
|
|

Overview
- Mutations are alterations in a cell's genome.
- Mutations may have endogenous causes (e.g., errors in DNA replication, cell division, and/or DNA repair mechanisms) or exogenous ones (e.g., a variety of physical, chemical, and biological agents ).

Mutations according to the affected cell population
- Germline mutation (gametic mutation): a mutation of germline cells that can be passed on to offspring
-
Somatic mutation (acquired mutation): a mutation of somatic cells that typically affects only one allele of a gene
- Does not occur in germline cells and, therefore, cannot be passed on to offspring.
- A common mechanism of carcinogenesis
-
Mosaicism: the presence of two or more populations of cells within an organism, each with a different genetic composition
-
Chromosomal mosaicism
- The presence of cell populations with different karyotypes in one organism
- Example: sex chromosome mosaicism is frequently seen in Turner syndrome (i.e., one population of XO cells and one population of XX cells)
-
Gonadal mosaicism
- The selective presence of a mutation in individual germ cells
- Caused by a mutation in the DNA of a primordial germ cell during mitosis
- Clinical application: Suspect this type of mosaicism if no blood relatives of the affected individual have the condition.
-
Somatic mosaicism
- The selective presence of a mutation in individual somatic cells
- Caused by a mutation during mitosis after fertilization
- Usually, multiple tissues or organs are affected
- Example: McCune-Albright syndrome
-
Chromosomal mosaicism
- Chimerism: The presence of two genetically distinct cell lines that arise from two different zygotes that fused into one single embryo.
-
Chromosomal instability: a chromosomal state characterized by increased susceptibility to mutations
- Caused by mutations of DNA repair genes
- Results in multiple chromosomal translations, inversions, and deletions among daughter cells
- Examples: Fanconi anemia, ataxia-telangiectasia
-
Loss of heterozygosity (LoH): loss of a normal allele of a gene with the exclusive expression of the abnormal allele
- The occurrence of LoH in tumor suppressor genes leads to malignant transformation of the cell.
- Example: Lynch syndrome
-
Two-hit hypothesis: states that two mutations (i.e., “hits”) must occur in the cellular DNA of tumor suppressor genes to induce oncogenesis
- First hit: One copy of a tumor suppressor gene is inactivated by mutation or epigenetic changes.
- The cell becomes heterozygous.
- The second allele is functional and produces a normal tumor suppressor protein.
- Second hit: The second copy of a tumor suppressor gene is inactivated by the mutation.
- LoH occurs (the cell becomes homozygous)
- No tumor suppressor protein is produced leading to increased risk of oncogenesis
- Does not apply to oncogenes
- Examples: retinoblastoma, Li-Fraumeni syndrome, Lynch syndrome, familial adenomatous polyposis
- First hit: One copy of a tumor suppressor gene is inactivated by mutation or epigenetic changes.

Terminology of chromosomal abnormalities
| Most common terms of chromosomal abnormalities | |||
|---|---|---|---|
| Abbreviation | Term | Example | Interpretation |
| del | Deletion | 46,XY, del(p5) | Deletion of the short arm of chromosome 5 in a male individual (e.g., cri-du-chat syndrome) |
| dup | Duplication | 46,XX, dup(q3) | Duplication of the long arm of chromosome 3 in a female individual |
| inv | Inversion | 46,XY, inv(3)(p23q27) | Pericentric inversion of the chromosome 3 segment with breakpoints at position 23 on the short arm and 27 on the long arm in a male individual |
| t | Translocation | 46,XY, t(14;18)(q32;q21) | Translocation between position 32 on chromosome 14 and position 21 on chromosome 18 in a male individual (e.g., follicular lymphoma) |
| rob | Robertsonian translocation | 46,XX, rob(14;21) | Chromosomal translocation with fusion of the long arms of the acrocentric chromosomes 14 and 21 in a female individual. The short arms of the two chromosomes involved are lost. |
| / | Mosaicism | 45,X/46, XX | Presence of a normal cell population and one with X monosomy in a female individual (e.g., Turner syndrome) |
Chromosomal aberrations
Introduction
- Chromosomal aberrations are mutations affecting large segments of DNA.
- Numerical abnormalities can be visualized on a karyogram, while structural chromosomal defects can be detected using fluorescence in situ hybridization (FISH).
- See “Chromosome testing” in “Laboratory methods.”
Subtypes of chromosomal aberrations
-
Numerical chromosomal aberrations: the presence of an abnormal number of copies of a single chromosome, which is usually caused by the failure of homologous chromosomes to separate during mitosis or meiosis, also known as nondisjunction
- Aneuploidy: an abnormal number of chromosomes or parts of a chromosome within the cell
- Hypoploidy: the presence of fewer chromosomes within a cell compared to the expected number
- Polyploidy: a state in which cells have more than two paired sets of chromosomes
-
Monosomy
- Presence of a single copy of a chromosome
- Usually results in embryonic death due to high probability of recessive trait expression of the respective chromosome
- Exception: Turner syndrome, which is characterized by a 45,XO genotype)
-
Hyperploidy: the presence of extra chromosomes within a cell
- Trisomy: the presence of a triplicate instead of a duplicate set of chromosomes (e.g., trisomy 21, trisomy 13, trisomy 18)
- Polysomy: the presence of ≥ 3 copies of a chromosome in a cell (e.g., trisomy, tetrasomy, pentasomy)
-
Structural chromosomal aberrations: an alteration of a chromosome structure with an identical number of chromosomes
-
Deletion is defined as a loss of a chromosome segment. Examples include:
- Cri-du-chat syndrome, which is characterized by 46,XX, del(5)
- Myelodysplastic syndrome, which is characterized by 5q deletion
- Duplication: duplication of a chromosome segment
- Inversion: chromosomal rearrangement involving end-to-end reversal of a chromosomal segment (e.g., 46,XY, inv(3)(p23q27))
- Chromosomal translocation: relocation of one chromosome segment onto another (nonhomologous) chromosome
-
Deletion is defined as a loss of a chromosome segment. Examples include:



Types of chromosomal translocations
All translocations are classified as structural chromosomal aberrations.
- Balanced translocation: a type of translocation in which no genetic material is lost or duplicated, thus expressing a normal phenotype
-
Unbalanced translocation
- A type of translocation in which genetic material is lost or duplicated, thus expressing an abnormal phenotype
- Unbalanced translocations can result in chromosomal imbalance (e.g., Patau syndrome), multiple malformations, stillbirth, and repeated miscarriages
-
Robertsonian translocation: a chromosomal translocation that involves the fusion of the long arms of two acrocentric chromosomes at the centromere with resulting loss of the short arms of the involved chromosomes
- One of the most frequent translocations [4]
- May be balanced or unbalanced
- Example: Unbalanced 46,XY, rob(14;21) is a possible mechanistic cause of Down syndrome.
-
Balanced Robertsonian translocation: translocation of the long arm of chromosome 21 to the long arm of chromosome 14 with the elimination of the respective short arms
- Karyogram shows a total number of 45 chromosomes
- Results in a normal phenotype
- Affected individuals inherit a balanced translocation from their phenotypically normal parent.
- Pregnancies with balanced translocations have an increased risk of miscarriage. [5]
- Children of carriers of balanced translocations are at higher risk of acquiring unbalanced translocation
-
Unbalanced Robertsonian translocation: clinical features of trisomy 21 caused by inheritance of a translocation chromosome and a normal chromosome
- Although there are only 46 chromosomes present, three copies of genetic material from chromosome 21 exist
- Results in the karyotypes 46,XX,+21,t(14;21) and 46,XY,+21,t(14;21)
- Reciprocal translocation: a translocation between nonhomologous chromosomes (e.g., Philadelphia translocation)
| Overview of common chromosomal translocations | ||
|---|---|---|
| Translocation | Gene product | Associated conditions |
| t(9;22) |
|
|
| t(8;14) |
|
|
| t(14:18) |
|
|
| t(11;14) |
|
|
| t(11;18) |
|
|
| t(15;17) |
|
|
| t(12;21) |
|
|
| t(11;22) |
|
|



Other chromosomal aberrations
-
Uniparental disomy: a chromosomal abnormality in which offspring receive two copies of one chromosome from one parent and no copies from the other parent
- May be caused by errors in meiosis I (i.e., heterodisomy), meiosis II (i.e., isodisomy), or trisomic rescue
- Heterodisomy: error in meiosis I → two different homologous chromosomes from one parent passed to offspring
-
Isodisomy can have two different causes:
- Error in meiosis II → identical homologous chromosomes from one parent passed to offspring
- Postzygotic chromosomal duplication leads to duplication of one chromosome of one pair and subsequent loss of the other
- Usually results in normal phenotype and euploidy in affected individuals
- Should be suspected if an individual presents with an autosomal recessive condition but only one parent is a carrier
-
Examples
- Angelman syndrome (5% of cases)
- Prader-Willi syndrome (25% of cases)
- May also result from trisomy rescue
- When a cell containing three copies of a chromosome from nondisjunction loses one of those chromosomes, resulting in two chromosomes
- If both of the remaining chromosomes are from the same parent, this results in uniparental disomy
Uniparental disomy cannot be detected via karyotyping because the number of chromosomes is normal and there is no loss of genetic material.
HeterodIsomy: meiosis I error; IsodIsomy: meiosis II error
12–345: the chromosomes most frequently involved in Robertsonian translocations are chromosomes 21, 22, 13, 14, and 15.

Gene mutations
Types of gene mutations
-
Point mutation: alteration of a single DNA base pair
- Genetic transition: the replacement of one purine with another purine (e.g., G to A), or the replacement of a pyrimidine with another pyrimidine (e.g., T to C)
- Genetic transversion: the replacement of a purine with a pyrimidine (e.g., A to C, A to T, G to C, G to T) and vice versa
- Deletion: loss of one or more base pairs
-
Splice site mutation
- A genetic mutation at the specific site in between exons and introns that may cause changes in splicing that result in the inclusion of introns or the loss of exons
- Can have a variable effect on the phenotype, depending on the exact location of the mutation
- Insertion: addition of one or more base pairs
- Substitution: one or more base pairs are replaced by different base pairs
-
Trinucleotide repeat expansion
- Increased repetition of base triplets that leads to faulty protein synthesis or folding
- Characterized by genetic anticipation
| Trinucleotide repeat expansion diseases | |||||
|---|---|---|---|---|---|
| Mode of inheritance | Affected gene | Chromosome | Trinucleotide repeat | Typical features | |
| Huntington disease | Autosomal dominant | HTT | 4 | CAG | Chorea, akinesia, cognitive decline, behavioral changes |
| Fragile X syndrome | X-linked dominant | FMR1 | X | CGG | Large protruding chin, large genitalia (testes), hypermobile joints, mitral valve prolapse |
| Myotonic dystrophy | Autosomal dominant | DMPK | 19 | CTG | Cataracts, premature hair loss in men, myotonia, arrhythmia, gonadal atrophy (men), ovarian insufficiency (women) |
| Friedreich ataxia | Autosomal recessive | FXN | 9 | GAA | Ataxic gait, dysarthria, kyphoscoliosis, hypertrophic cardiomyopathy |

Classification of gene mutations
Grade of mutational severity in ascending order: silent < missense < nonsense < frameshift
-
Frameshift mutation
- A shift in the reading frame caused by the insertion or deletion of a number of nucleotides not divisible by 3 that leads to modified amino acid coding in the gene segments downstream
- Results in the synthesis of shorter or longer proteins with a modified or absent function
- Examples: Tay-Sachs disease, Duchenne muscular dystrophy
-
Nonframeshift mutation
- A mutation of a gene with the insertion or deletion of a number of nucleotides that is divisible by three.
- These types of mutations tend to be less severe than frameshift mutations, as the missing (or added) codons often lead to partially functional peptides.
-
Nonsense mutation
- The substitution of a nucleotide that produces a stop codon (UAA, UGA, UAG) and leads to alterations in the splicing process with early termination of translation
- Typically results in nonfunctional proteins
-
Missense mutation
- A point mutation resulting in the formation of a triplet that codes for another amino acid
- Considered a conservative missense mutation when the new amino acid is similar in chemical structure to the original amino acid
- Example: sickle cell disease (glutamate is substituted with valine)
-
Silent mutation
- A point mutation that forms a triplet that codes for the same amino acid
- Often involves a base change at the tRNA wobble position (3rd position of the codon)
- In-frame deletion or insertion: deletion or insertion of three, six, nine, or more base pairs (always in triplets) without a shift in the reading frame, but with deletion or insertion of one, two, three, or more amino acids in the protein during translation
- Loss-of-function mutation: a mutation resulting in the expression of the gene product with decreased or absent function
- Gain-of-function mutation: a mutation that leads to either the expression of the larger amount of the gene product or increased function of the expressed gene product
-
Splice mutation: an alteration (especially point mutations) in the nucleotide sequence required for splicing (e.g., the exon-intron border or at the junction)
- Results in defective mRNA (e.g., due to a retained intron) → shortened proteins that are either defective or exert an altered function
- Examples include:
- Some forms of β-thalassemia
- Gaucher disease
- Marfan syndrome
- Dementia
- Epilepsy
-
Dominant-negative mutation
- A gene mutation that produces a nonfunctional protein that exerts a dominant effect
- This nonfunctional protein impairs the function of the normal protein encoded by the wild-type allele in heterozygous individuals (e.g., mutant, nonfunctional p53, binds DNA and prevents the attachment of the functional p53 protein) [6]
Compared to missense or silent mutations, nonsense and frameshift mutations lead to fundamental structural changes of the coded proteins. Consequently, these mutations result in more severe disease manifestations.
STOP the NONSENSE: NONSENSE mutations create early STOP codons in the RNA.

Examples of genetic disorders by chromosome
| Chromosome | Disorders |
|---|---|
| 3 |
|
| 4 |
|
| 5 |
|
| 6 |
|
| 7 |
|
| 8 |
|
| 9 |
|
| 11 |
|
| 13 |
|
| 14 |
|
| 15 |
|
| 16 |
|
| 17 |
|
| 18 |
|
| 21 |
|
| 22 |
|
| X |
|
“Friedrich gave the fragile hunter my tonic”: Friedreich ataxia, fragile X syndrome, Huntington disease, and myotonic dystrophy are examples of trinucleotide expansion disorders.
In Huntington disease, a CAG trinucleotide repeat leads to Chorea, Akinesia, and Grotesque behavior.
In fragile X syndrome, a CGG trinucleotide repeat leads to an X-tra large Chin and Giant Genitalia.
In myotonic dystrophy, a CTG trinucleotide repeat leads to Cataracts, Thinning hair (premature hair loss), and Gonadal atrophy.
In Friedreich ataxia, a GAA trinucleotide expansion leads to an ataxic GAAit.
Overview
- Epigenetics is the study of how an individual's surrounding environment and behaviors influence gene expression and regulation.
- Epigenetic modifications influence the activation or deactivation of genes through reversible alterations to the chromatin structure.
- Gene expression or repression is determined by chemical modifications of DNA bases (e.g., methylation) and histone proteins (e.g., various covalent modifications), which are carried out by specialized enzymes.
- Epigenetic modifications do not affect the DNA sequence or structure of DNA molecules.
- See “Nucleotides, DNA, and RNA.”
Main mechanisms of epigenetic regulation
DNA methylation [7]
-
Definition
- DNA methylation is the linkage of CH3 groups to specific DNAcytosine bases with the subsequent formation of 5-methylcytosine.
- DNA methylation is facilitated by DNA methyltransferases, a conserved enzyme family of cytosine methylases critical for epigenetic regulation that transfer a methyl group to DNA.
- The resulting DNA segment has an unchanged genetic code but differs in epigenetic markers (e.g., methylation at transcriptional start sites) that alter DNA expression.
- Results in transcriptional inhibition of the methylated gene
-
Process of methylation
- A newly synthesized DNA strand is methylated after DNA replication (using the matrix strand as a template).
-
In vertebrates, methylation most commonly occurs at CpG islands, a region of DNA enriched for repeating segments of a cytosine nucleotide that is followed by a guanine nucleotide, linked by a phosphodiester bond.
- CpG islands are approx. 1000 base pairs in length
- Many gene promoter regions are found within CpG islands
- Methylation within the CpG islands will usually lead to repression of gene transcription.
- Inheritance: The pattern of DNA methylation (e.g., specific methylation of CpG island transcription start sites) can be inherited during somatic cell division and may be responsible for particular genomic processes (e.g., genomic imprinting). [7]
-
Examples
- X chromosome inactivation [8]
- Genomic imprinting [9]
- Cancerogenesis [10]
- Aging [11]
- Transposable element repression [12]
Epigenetic regulation mechanisms: Acetylation Activates DNA; Methylation Mutes DNA.

Histone modification [13][14]
-
Definition
- The covalent bonding and chemical modification of histone proteins with various molecular moieties that alters the dynamic structure of chromatin and influence genomic regulation.
- Results in the modification of the gene expression
-
Types of modifications: See “Chromatin” in “Nucleotides, DNA, and RNA.”
- Acetylation: ↑ DNA transcription
- Deacetylation: ↓ DNA transcription
- Methylation (of lysine and arginine residues): increased or decreased gene transcription
- Phosphorylation
- Deamination
- Ubiquitination
- Sumoylation
- ADP ribosylation
- Other modifications include histone tail clipping, citrullination, and serotonylation.
- Inheritance: the histone modification pattern is passed on to daughter cells during cell division
-
Examples
- Carcinogenesis: dysregulated histone deacetylases (HDACs) can decrease the transcription of cell cycle inhibitors (e.g., p21 in colorectal cancer) or cell differentiation factors (e.g., Runx1 in leukemia) [15]
- Aging
Regulatory RNA [16]
-
Definition
- A diverse class of RNA molecules that play a role in the regulation of chromatin structure and gene expression
- These RNA molecules are typically noncoding and do not produce translated protein products.
- Gene regulation occurs via RNA-interference (RNAi) pathways (i.e., molecular pathways that use PIWI and Argonaute proteins to influence histone and DNA modifications with subsequent transcriptional inhibition).
-
Types of regulatory RNAs: See “RNA: Structure and characteristics” in “Nucleotides, DNA, and RNA.”
- Long noncoding RNAs (lncRNA)
- Small interfering RNAs (siRNA)
- Micro RNAs (miRNA)
- PIWI-interacting RNA (piRNA)
-
Examples [17]
- X chromosome inactivation
- Genomic imprinting
- Transposon repression and silencing
Examples of processes regulated by epigenetic mechanisms
X inactivation (lyonization)
-
Definition
- Inactivation of one of the X chromosomes in individuals with two or more X chromosomes (e.g., female individuals or male individuals with Klinefelter syndrome).
- The selection of which X chromosome is inactivated, occurs randomly.
- Prevents a toxic double-dose of X chromosome gene products
- Occurs early during embryogenesis with the affected X chromosome remaining inactive for the lifetime of the cell.
-
Mechanism [18]
- Multiple mechanisms of lyonization have been proposed including:
- DNA methylation
- Histone posttranslational modifications
- RNAi via lncRNAs such as X-inactive specific transcript RNA (Xist RNA), a functional RNA product that coats the affected X chromosome and serves as the initiating and, hence, most important event in the inactivation process.
-
Results in a Barr body: contains the inactivated X chromosome packaged as heterochromatin
- Transcriptionally inactive
- Located on the periphery of the nucleus
- Although most genes on the Barr body are inactive, some genes escape lyonization and remain active.
- Multiple mechanisms of lyonization have been proposed including:
-
Manifestation of X-linked disorders in female individuals
- Female individuals will only express alleles or genes located on the active X-chromosome.
- Therefore, the extent to which heterozygous female carriers of X-linked recessive disorders express phenotypic characteristics of the disease depends on the genetic inactivation pattern of the mutant versus the normal X-chromosome.
- This leads to phenotypic variation among heterozygous female carriers of X-linked disorders (e.g., one female carrier of an X-linked disorder may be completely asymptomatic, while another has severe manifestations of the involved disease).
- In female individuals who are homozygous for an X-linked recessive disorder, it does not matter which chromosome is inactivated
Genomic imprinting [19]
-
Definition: : a mechanism of gene regulation in which one allele of a gene is silenced and imprinted while the other allele is expressed depending on which parent it was inherited from (i.e., parent-of-origin effect)
- Must uphold the four principles of epigenetic imprinting:
- The product of gene transcription must be affected.
- The imprinting must be heritable in a somatic lineage.
- The process of genomic imprinting is initiated during gametogenesis.
- The imprint must be eliminated in the germline for sex-specific reprogramming to occur in the next generation of gametes.
- Must uphold the four principles of epigenetic imprinting:
-
Mechanism
- Depending on the gene, DNA methylation results in epigenetic silencing of either maternal or paternal chromosomes (e.g., if the paternal gene is silenced, only the maternal gene is expressed).
- Methylation results in regions called “differentially methylated regions” (DMRs)
- DMRs are the essential imprinting control regions that are responsible for allelic expression.
- Imprinting control regions often exist within gene promoters.
- In imprinting disorders, the expressed allele may be deleted, mutated, or not expressed at all.
-
Examples of genomic imprinting disorders
- Angelman syndrome
- Prader-Willi syndrome

Overview
- Definition: the study of inherited traits or disorders and their phenotypic variability over several generations in a group of blood-related individuals by way of a pedigree chart, which depicts that group's genetic history in a family tree
-
Elements
- Circles: female individuals
- Squares: male individuals
- Lines between circles and squares: familial relationship
- Roman numerals: generations
- Arabic numbers: children of a generation in order of birth
- Affected family members and carriers (i.e., heterozygous individuals who have the allele but are not phenotypically affected) are represented by shaded symbols.

A basic methodological approach to pedigree analysis
-
Question 1: Does every affected family member have an affected parent?
- Yes: dominant inheritance of the trait
- No: recessive inheritance of the trait
-
Question 2: Are the majority of affected family members male?
- Yes: most likely X-linked recessive inheritance
-
No: Proceed to the following questions and subsequent answers.
- Question 2a: Do all affected male family members have an affected mother?
- Question 2b: Do all affected male family members have unaffected sons?
-
Question 2c: Do all affected male family members have affected daughters?
- If Questions 2a, 2b, and 2c have all been answered in the affirmative, the disease most likely follows an X-linked dominant pattern of inheritance.
- If Question 1 has been answered in the affirmative and either Question 2a, 2b, or 2c has been answered in the negative, the disorder is most likely autosomal dominant.
- If Question 2 and Questions 2a, 2b, and 2c have all been answered in the negative, the disorder is most likely autosomal recessive.



Overview
- Definition: a mode of inheritance that only requires one allele from a nonsex chromosome, passed on from either mother or father, for the phenotypical expression of a trait or disorder in offspring
- With regard to the inheritance patterns (both autosomal and X-linked), capital letters are used to describe the dominant alleles that cause the trait/disorder, while lowercase letters are used to describe the recessive alleles that do not cause the trait/disorder.
- Autosomal dominant (AD) disorders are usually due to mutations in structural genes (i.e., essential genes that code for RNA or protein products such as enzymes or cellular structural proteins).
- Every child with one parent who is affected and heterozygous has a 50% probability of inheriting the allele that causes the trait and, therefore, the associated trait or disorder (see tables and pedigree chart below).
- Autosomal dominant disorders are pleiotropic and their expressivity is often variable.
- Knowing about an individual's family history can provide vital information for diagnosis, since autosomal dominant conditions usually affect multiple generations, regardless of sex.
Examples of AD inheritance patterns
- Homozygous parents: children have a 100% probability of inheriting the allele that causes the trait/disorder.
| AD inheritance pattern in homozygous parents | |||
|---|---|---|---|
| Homozygous parent (affected) | |||
| N | N | ||
| Homozygous parent (unaffected) | n | Nn (affected) | Nn (affected) |
| n | Nn (affected) | Nn (affected) | |
- One heterozygous and one homozygous parent: Children have a 50% probability of inheriting the allele that causes the trait/disorder.
| AD inheritance pattern in heterozygous and homozygous parent | |||
|---|---|---|---|
| Heterozygous parent (affected) | |||
| N | n | ||
| Homozygous parent (unaffected) | n | Nn (affected) | nn (unaffected) |
| n | Nn (affected) | nn (unaffected) | |
- Heterozygous parents: Children have a 75% probability of inheriting the allele that causes the trait/disorder.
| AD inheritance pattern in heterozygous parents | |||
|---|---|---|---|
| Heterozygous parent (affected) | |||
| N | n | ||
| Heterozygous parent (affected) | N | NN (affected) | Nn (affected) |
| n | Nn (affected) | nn (unaffected) | |
An autosomal dominant disease with complete penetrance will always manifest with clinical features in every generation.
Examples of AD disorders
- Achondroplasia
- Autosomal dominant polycystic kidney disease (ADPKD)
- Ehler-Danlos syndrome
- Familial adenomatous polyposis
- Familial hypercholesterolemia
- Hereditary spherocytosis
- Huntington disease
- Li-Fraumeni syndrome
- Marfan syndrome
- Multiple endocrine neoplasias
- Myotonic muscular dystrophy
- Neurofibromatosis type 1
- Neurofibromatosis type 2
- Osler-Weber-Rendu syndrome
- Osteogenesis imperfecta
- Tuberous sclerosis
- Von Hippel-Lindau disease


Overview
- Definition: a mode of inheritance that requires two copies of an allele from nonsex chromosomes, one from the mother and one from the father, for the phenotypical expression of a trait or disorder in offspring
- With regards to recessive inheritance patterns (both autosomal and X-linked), lowercase letters are used to describe the recessive alleles that cause trait/disorder, while capital letters are used to describe dominant alleles that do not cause trait/disorder.
- Autosomal recessive (AR) disorders manifest early in childhood and typically feature more severe symptoms than autosomal dominant disorders (e.g., autosomal recessive polycystic kidney disease vs. autosomal dominant polycystic disease).
- Normally seen only in one generation of a pedigree.
- Families arising from consanguineous partnerships have an increased risk for autosomal recessive diseases.
- Autosomal recessive diseases usually involve enzyme defects.
- Patterns of inheritance occur via two possible mechanisms:
- Homozygosity for the allele that causes the trait/disorder
- Compound heterozygosity
Examples of AR inheritance patterns
- Homozygous parents: no children will be affected, but all will be carriers
| AR inheritance pattern in homozygous parents | |||
|---|---|---|---|
| Homozygous parent (unaffected) | |||
| N | N | ||
| Homozygous parent (affected) | n | Nn (carrier) | Nn (carrier) |
| n | Nn (carrier) | Nn (carrier) | |
- One heterozygous and one homozygous parent: All children inherit the allele that causes the trait or disorder, but only 50% will express the trait while other 50% will be carriers.
| AR inheritance pattern in heterozygous and homozygous parent | |||
|---|---|---|---|
| Heterozygous mother (carrier) | |||
| N | n | ||
| Homozygous father (affected) | n | Nn (carrier) | nn (affected) |
| n | Nn (carrier) | nn (affected) | |
-
Heterozygous parents
- Half of the children will be carriers, 25% will express the trait, and 25% will not express the trait.
- Healthy individuals with an affected sibling (nn) have a two-thirds-probability of being a carrier (Nn, Nn, or NN).
| AR inheritance pattern in heterozygous parents | |||
|---|---|---|---|
| Heterozygous parent (carrier) | |||
| N | n | ||
| Heterozygous parent (carrier) | N | NN (unaffected) | Nn (carrier) |
| n | Nn (carrier) | nn (affected) | |

Examples of AR disorders
- Oculocutaneous albinism
- ARPKD
- Cystic fibrosis
- Friedreich ataxia
- Glycogen storage diseases
- Hemochromatosis
- Kartagener syndrome
- Mucopolysaccharidoses (except Hunter syndrome, which is an X-linked recessive disorder)
- Phenylketonuria
- Sickle cell anemia
- Sphingolipidoses (except Fabry disease, which is an X-linked recessive disorder)
- Thalassemias
- Wilson disease

Overview
- Definition: a mode of inheritance that requires two copies of an allele on the X chromosome, one from the mother and one from the father, for the phenotypical expression of a trait or disorder in offspring
- X-linked recessive (XR) inheritance leads to the expression of the phenotype in all male children who inherit the mutated allele.
-
Female individuals are more frequently carriers (unaffected) of X-linked inherited disorders than male individuals.
- Female individuals typically require the inheritance of one mutated allele from their father and one allele from their mother (affected homozygous) to phenotypically express XR disorders.
- Therefore, it is more common for female individuals to be heterozygous carriers of the allele.
- However, female individuals may also express XR phenotypes if the nonaffected X chromosome is inactivated in the majority of cells (see “Manifestation of X-linked disorders in female individuals” above).
- Individuals with Turner syndrome only have one X chromosome and are, therefore, more susceptible to X-linked recessive disorders
- Male-to-male inheritance is impossible.
- Male individuals tend to develop a more severe form of the XR disease.
- This type of inheritance frequently skips generations.
Examples of XR inheritance patterns
-
Heterozygous (carrier) mother and hemizygous (unaffected) father
- Children have a 50% probability of inheriting the X chromosome that causes the trait/disorder.
- Sons have a 50% probability of inheriting the trait or disorder.
| XR inheritance pattern in heterozygous (carrier) mother and hemizygous (unaffected) father | |||
|---|---|---|---|
| Heterozygous mother (carrier) | |||
| x | X | ||
| Hemizygous father (unaffected) | X | Xx (daughter, carrier) | XX (daughter, unaffected) |
| Y | xY (son, affected) | XY (son, unaffected) | |
-
Heterozygous (carrier) mother and hemizygous (affected) father
- Children have a 75% probability of inheriting the X chromosome responsible for the trait/disorder.
- Children have a 50% probability of developing the trait/disorder.
| XR inheritance pattern in heterozygous (carrier) mother and hemizygous (affected) father | |||
|---|---|---|---|
| Hemizygous father (affected) | |||
| x | Y | ||
| Heterozygous mother (carrier) | X | Xx (daughter, carrier) | XY (son, unaffected) |
| x | xx (daughter, affected) | xY (son, affected) | |
-
Homozygous (unaffected) mother and hemizygous (affected) father
- Children have a 50% probability of inheriting the X chromosome that causes the trait/disorder.
- None of the children will be affected.
| XR inheritance pattern in homozygous (unaffected) mother and hemizygous (affected) father | |||
|---|---|---|---|
| Hemizygous father (affected) | |||
| x | Y | ||
| Homozygous mother (unaffected) | X | Xx (daughter, carrier) | XY (son, unaffected) |
| X | Xx (daughter, carrier) | XY (son, unaffected) | |
- Homozygous (affected) mother and hemizygous (affected) father: If both parents have the trait/disease then all children will invariably be affected.
| XR inheritance pattern in homozygous (affected) mother and hemizygous (affected) father | |||
|---|---|---|---|
| Hemizygous father (affected) | |||
| x | Y | ||
| Homozygous mother (affected) | x | xx (daughter, affected) | xY (son, affected) |
| x | xx (daughter, affected) | xY (son, affected) | |

Examples of XR disorders
- Becker muscular dystrophy
- Bruton agammaglobulinemia
- Color blindness
- Duchenne muscular dystrophy
- Fabry disease
- G6PD deficiency
- Hemophilia A
- Hemophilia B
- Hunter syndrome
- Lesch-Nyhan syndrome
- Ocular albinism
- Ornithine transcarbamylase deficiency
- Wiskott-Aldrich syndrome


Overview
- Definition: a mode of inheritance that only requires one copy of a mutated allele on the X chromosome, from either the mother or father, for the phenotypical expression of the trait or disorder in offspring
- In X-linked dominant (XD) inheritance, male and female individuals have an equal probability of inheriting the trait or disorder.
- Because female individuals have two X chromosomes, the inheritance of an X-linked dominant disorder typically manifests in a less severe form than in male individuals.
Examples of XD inheritance patterns
- Heterozygous mother and hemizygous (unaffected) father: Children have a 50% probability of inheriting the trait/disease.
| XD inheritance pattern in heterozygous mother and hemizygous (unaffected) father | |||
|---|---|---|---|
| Heterozygous mother (affected) | |||
| X | x | ||
| Hemizygous father (unaffected) | x | Xx (daughter, affected) | xx (daughter, unaffected) |
| Y | XY (son, affected) | xY (son, unaffected) | |
- Homozygous mother and hemizygous (unaffected) father: All the children will inherit the trait/disease.
| XD inheritance pattern in homozygous mother and hemizygous (unaffected) father | |||
|---|---|---|---|
| Homozygous mother (affected) | |||
| X | X | ||
| Hemizygous father (unaffected) | x | Xx (daughter, affected) | Xx (daughter, affected) |
| Y | XY (son, affected) | XY (son, affected) | |
- Heterozygous mother and hemizygous (affected) father: Children have a 75% probability of inheriting the trait/disease.
| XD inheritance pattern in heterozygous mother and hemizygous (affected) father | |||
|---|---|---|---|
| Hemizygous father (affected) | |||
| X | Y | ||
|
Heterozygous mother (affected) |
X | XX (daughter, affected) | XY (son, affected) |
| x | Xx (daughter, affected) | xY (son, unaffected) | |
-
Homozygous (unaffected) mother and hemizygous (affected) father
- All daughters will be affected.
- Sons are invariably unaffected.
| XD inheritance pattern in homozygous (unaffected) mother and hemizygous (affected) father | |||
|---|---|---|---|
| Hemizygous father (affected) | |||
| X | Y | ||
| Homozygous mother (unaffected) | x | Xx (daughter, affected) | xY (son, unaffected) |
| x | Xx (daughter, affected) | xY (son, unaffected) | |

Examples of XD disorders
- Alport syndrome
- Fragile X syndrome
- Hypophosphatemic rickets
- Rett syndrome
Mitochondrial inheritance
- Definition: a mode of inheritance that involves the transmission of mutated alleles in the mitochondrial genome through maternal lineage only
-
Features
- Diseases caused by mutations in mitochondrial DNA are only passed down to offspring by the mother.
- The inheritance pattern is hypothesized to occur for a number of reasons, including: [20]
- Paternal sperm does not bring a significant number of mitochondria to the oocyte during fertilization.
- Paternal mitochondria are diluted during cellular division and mitosis.
- Paternal mitochondria may be destroyed through cellular mechanisms, such as ubiquitination.
- Each mitochondrion has multiple copies of DNA (mtDNA), and each cell has many mitochondria.
- Typically without mutations, all copies of mtDNA in each mitochondrion will be identical (i.e., homoplasmy).
-
Therefore, mutations cause a state of heteroplasmy.
- The presence of affected and unaffected mtDNA within different cells leads to variable disease expression.
- Severity often correlates with the proportion of mutated mtDNA copies.
-
Examples
- Mitochondrial myopathies (e.g., MELAS syndrome)
- Leber hereditary optic neuropathy


Polygenic inheritance
- Definition: a trait controlled by the interaction of two or more genes at different loci, without interaction with the environment
-
Examples
- Skin pigmentation eye color, and most anthropometric traits (e.g., height, weight)
- Polygenic inheritance is involved in the development of many otherwise unrelated disorders (e.g., type 1 diabetes, type 2 diabetes, hypertension, androgenic alopecia, atopy, psoriasis, schizophrenia, Alzheimer disease)
Multifactorial inheritance disorders (MID)
- Definition: disorders that result from a combination of mutations in multiple genes and environmental factors (e.g., type 2 diabetes mellitus, cleft palate, neural tube defects, schizophrenia, coronary artery disease)
-
Features
- Commonly manifest with the Carter effect [21]
- Individuals of the less commonly affected sex are more likely to pass on the disorder to their children if they develop the disease.
- It is hypothesized the group less commonly affected possesses a higher number of susceptibility genes and the trait/disorder will, therefore, manifest less frequently, requiring more genetic loci to be affected.
- However, the numerical increase in susceptibility genes leads to an increased probability of passing on mutated alleles to offspring.
- Population groups with a certain heritage are more commonly affected compared to the population at large (e.g., Hispanic, Ashkenazi Jewish, West African).
- One gender is more frequently affected.
- Isolated occurrence is possible, but familial clustering is frequent.
- Commonly manifest with the Carter effect [21]
- Index case: the first person of a family to develop the trait/disorder in question
- Threshold effect: Effect observed in some MIDs, in which the disorder only develops when genetic predispositions and external factors combine to reach a certain threshold value.
- Gene-environment interaction: genetic predisposition affects susceptibility to the effects of environmental factors (e.g., individuals with a family history of type II diabetes may never develop the disease if they maintain a healthy lifestyle).
Terminology
- Population (genetics): a group of individuals that interbreed and live on the same territory at the same time point
- Gene pool: a collection of all genes found in a population
- Genetic variation: a variation of the genome between organisms within one species
Genetic variation [22][23]
The following phenomena lead to changes in genetic variation.
- Mutation-selection equilibrium: a balance between the rate of occurrence of deleterious alleles (alleles, which decrease the fitness of an individual) in a population and their elimination through the selection processes
-
Genetic drift
- A change in allele frequencies in a population that occurs by chance in a finite population due to random sampling
- Typically leads to a decrease in genetic variation
- Can be encountered in the following scenarios:
-
Founder effect
- A reduction in genetic variation resulting from the establishment of a new population by a small subset of a larger population
- Example: increased incidence of maple syrup disease, polydactyly, and other conditions in Amish individuals
-
Genetic bottleneck
- A decrease in the gene pool and genetic variation caused by a dramatic decrease in the size of a population (e.g., due to death or reduced rate of reproduction)
- Increases risk of extinction of alleles from the population and accumulation of recessive traits
-
Founder effect
-
Natural selection
- A process through which the population frequency of traits that increase the chance of survival of an organism increases and the frequency of traits that reduce it decreases
- If only a small number of alleles of a gene or homozygosity is beneficial, it will lead to a decrease in genetic variation
- If having multiple alleles of a gene or being a heterozygote is beneficial (heterozygous advantage), genetic diversity will be maintained
- Example: there is an increased frequency of the sickle cell trait (heterozygosity for the sickle-cell allele) in the African population because it provides a relative resistance to malaria while causing only mild symptoms
- A process through which the population frequency of traits that increase the chance of survival of an organism increases and the frequency of traits that reduce it decreases
Heterozygote frequency
-
Definition
- The proportion of heterozygote carriers of an allele that causes a trait/disorder in the population
- Used to estimate a child's risk of a recessive inherited disorder if the genotype of the parents is unknown
-
Equation: The heterozygote frequency is calculated by using the Hardy-Weinberg law, a principle that states that genetic variation in a population remains constant under a set of idealized assumptions (including random mating and no migration, mutation, or selection).
-
Hardy-Weinberg equilibrium: (p+q)2 =p2 + 2pq + q2 = 1 (100%).
- The frequency of the independent alleles Aand a are represented by p and q, respectively, where p + q = 1.
- p2 = homozygote frequency of allele A
- q2 = homozygote frequency of allele a
- 2pq = heterozygote frequency (probability of carrying both an altered and an allele that does not cause the trait/disorder)
- For X-linked recessive disease, the frequency in male individuals = q and in female individuals = q2
-
The Hardy-Weinberg law is based on the biostatistically ideal assumptions that:
- There is no natural selection of alleles in the population.
- No mutations occur in the allele under investigation.
- There is random mating inside the population.
- The population is large enough to rule out the effects of genetic drift.
- There is no migration both outside and inside the population.
-
Hardy-Weinberg equilibrium: (p+q)2 =p2 + 2pq + q2 = 1 (100%).
-
Example: cystic fibrosis with an incidence of ∼ 1:2,500
- Calculate 2pq: 2pq = 2×1×1/50 = 1/25 (4%) heterozygote frequency
- Calculate p: If (p + q)2 = 1 then p + q = 1 and p = 1 – q = 1 – 1/50 = 0.98 (98%) ≈ 1
- Calculate q: If q2 = 1/2,500 then q = 1/50 = 0.02 (2%)
- Since cystic fibrosis is a recessive disorder, only homozygote carriers develop the disease. The incidence corresponds to the homozygote frequency q2.
| A (p) | a (q) | |
|---|---|---|
| A (p) | AA (p2) | Aa (pq) |
| a (q) | Aa (pq) | aa (q2) |

- Definition: introduction of genetic material into a cell to treat diseases by changing the expression of a gene or modifying cellular processes [24][25]
-
Indications
- Single-gene disorders (e.g., cystic fibrosis, galactosemia, spinal muscular atrophy)
- Neoplasms (e.g., melanoma, leukemia)
-
Modes of therapy delivery [26]
-
In-vivo
- Gene therapy is introduced directly into the body tissues.
- Usually targets nondividing cells (e.g., neurons)
-
Ex-vivo
- Cells are gathered from the patient or donor, modified outside the body, and returned back to the body.
- Usually targets dividing cells (e.g., white blood cells)
-
In-vivo
-
Methods of therapy transfer
- Viral vectors (e.g., lentiviruses, retroviruses)
- Liposomes
- Polymers
-
Electroporation
- Usage of a high-voltage electrical field for DNA delivery into cells.
- Electrical field change permeability of the cell membrane allows for passage of the substances with large molecular weight (e.g., nucleic acids).
| Examples of gene therapy agents | ||
|---|---|---|
| Drug | Mechanism | Indications |
| Onasemnogene abeparvovec |
|
|
| Voretigene neparvovec |
|
|
| Tisagenlecleucel |
|
|
| Alipogene tiparvovec |
|
|
| Overview of clinical genetic tests [27][28] | ||||
|---|---|---|---|---|
| Method | Indications | Benefits | Limitations | |
| Single-gene sequencing |
|
|
|
|
| Gene panel sequencing |
|
|
|
|
| Whole-exome sequencing [28] |
|
|
|
|
| Whole-genome sequencing |
|
|
||
| Chromosomal microarray |
|
|
|
|
| Karyotyping |
|
|
|
|